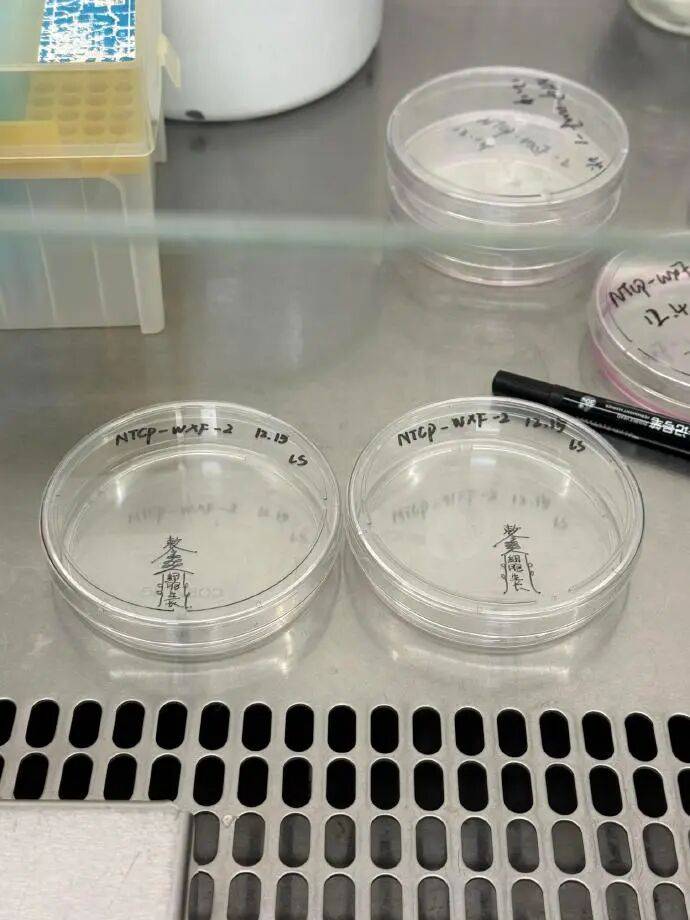

萌







哪兒偷來的尾巴@切開來是黑的蜜瓜

假如遮住的是“鼻”@靈感之源

成年就是無論睡多久都會覺得累@HeyWarWars

實驗室來了個老法師@學長陳新知



趕快拿走!@沒時間跟你們胡鬧了

老人的命也是命 /r/meirl/ 版

幸福

感受一下我閨蜜有多熱情,就問你吃不吃?

現在段子成本太高了

倉鼠那一瞬間的小王子,真的帥呆了

孩子去上學了,老公出差了,終於可以一個人嗨了

土耳其的國民女神Esra Bilgiç








上個廁所也要舞一段

萌







哪兒偷來的尾巴@切開來是黑的蜜瓜

假如遮住的是“鼻”@靈感之源

成年就是無論睡多久都會覺得累@HeyWarWars

實驗室來了個老法師@學長陳新知

趕快拿走!@沒時間跟你們胡鬧了

老人的命也是命 /r/meirl/ 版

幸福

感受一下我閨蜜有多熱情,就問你吃不吃?

現在段子成本太高了

倉鼠那一瞬間的小王子,真的帥呆了

孩子去上學了,老公出差了,終於可以一個人嗨了

土耳其的國民女神Esra Bilgiç








上個廁所也要舞一段

•
像不像你親戚給你介紹的對象,哈哈哈哈哈哈
-500miles-
♂
(0 bytes)
()
12/19/2025 postreply
12:00:52
•
萌貓真比銀造美女好看太多啦
-紅卡-
♀
(0 bytes)
()
12/19/2025 postreply
12:52:07
•
+100
-最西邊的島上-
♀
(0 bytes)
()
12/19/2025 postreply
14:00:51
•
實驗室來了個老法師?哈哈哈。跟一個來自於實驗室的神曲
-JoyAnna.-
♀
(716 bytes)
()
12/19/2025 postreply
13:12:59
•
土耳其女神不錯 可以演露西婭
-偶爾掉鏈子-
♀
(0 bytes)
()
12/19/2025 postreply
13:30:11
WENXUECITY.COM does not represent or guarantee the truthfCCPA ulness, accuracy, or reliability of any of communications posted by other users.
Copyright ©1998-2026 wenxuecity.com All rights reserved. Privacy Statement & Terms of Use & User Privacy Protection Policy